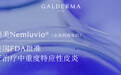
高德美Nemluvio®（奈莫利珠单抗）获美国FDA批准，用于治疗中重度特应性皮炎

高德美Nemluvio®(奈莫利珠单抗)获美国FDA批准,用于治疗中重度特应性皮炎
·美国约有7%的人口患有特应性皮炎,这是一种以持续瘙痒和反复出现皮损为特征的常见慢性炎症性皮肤病。1-4
·虽然目前的治疗方法可缓解部分症状和体征,但许多患者对已获批准的治疗方法反应欠佳,无法实现相同程度的瘙痒缓解和皮损清除。2,5-7
·Nemluvio®(奈莫利珠单抗)是首个获批特异性靶向IL-31受体α的单克隆抗体,可抑制IL-31的信号传导。IL-31是一种神经免疫细胞因子,可引发瘙痒,并在特应性皮炎的炎症和表皮功能失调中发挥作用。2,9-11
·此前,Nemluvio®(奈莫利珠单抗)已于2024年8月获得美国食品药品监督管理局(FDA)批准,用于治疗成人结节性痒疹。12
2024年12月13日,高德美宣布,美国食品药物监督管理局(FDA)已批准Nemluvio®(奈莫利珠单抗)用于治疗12岁及以上的中重度特应性皮炎患者,当局部处方疗法(包括局部外用糖皮质激素(TCS)和/或钙调磷酸酶抑制剂(TCI))无法充分控制病情时,可联合使用Nemluvio®(奈莫利珠单抗)。此前,美国FDA已于2024年8月批准Nemluvio®(奈莫利珠单抗)用于皮下注射治疗成人结节性痒疹。12
特应性皮炎影响着全球2.3亿多人,在美国约有7%的人口受其影响。2-4瘙痒常被视为最困扰患者的症状之一,87%的特应性皮炎患者表示他们渴望摆脱瘙痒,因此患者和医生都高度重视止痒速度。13-16特应性皮炎具有高度异质性,可伴有多种合并症,包括精神疾病和其他自身免疫或免疫介导的疾病。2,13,17-19因此,仍然需要更多新颖、有效的治疗方案,因为尽管目前可用的特应性皮炎治疗方法可改善某些症状和体征,但许多患者对已获批准的疗法反应欠佳,不能在相同程度上缓解瘙痒和清除皮损2,5-7。
Nemluvio®(奈莫利珠单抗)是首个获批能够特异性靶向IL-31受体alpha的单克隆抗体,可抑制IL-31的信号通路。8IL-31是一种神经免疫细胞因子,可引起瘙痒,并参与特应性皮炎的炎症过程和表皮功能失调。2,9-11
“Nemluvio®(奈莫利珠单抗)是我们基于科学创新研发管线中的一个典范,它是特应性皮炎患者的一个重要且有效的全新治疗选择,满足特应性皮炎患者的未尽之需。此次获得FDA批准是高德美发展历程中的又一个重要里程碑,它将加速我们美国组织的成长和皮肤治疗业务的持续发展,同时也彰显了我们致力于,在快速增长的皮肤科市场中为患者提供一流创新解决方案的坚定承诺。”高德美首席执行官FLEMMING ØRNSKOV表示。
此次获批是基于ARCADIA三期临床试验的积极成果。该试验针对1728名12岁及以上中度至重度特应性皮炎患者,评估了Nemluvio®(奈莫利珠单抗)与基础外用糖皮质激素(TCS)联合使用(无论是否联用钙调磷酸酶抑制剂(TCI)),相较于安慰剂组与外用糖皮质激素(TCS)联合使用(无论是否联用钙调磷酸酶抑制剂(TCI))的疗效和安全性。20
试验结果表明,每四周一次接受皮下注射Nemluvio®(奈莫利珠单抗),并与TCS联用(无论是否联用TCI),患者在两个共同主要终点的皮损清除率方面均有统计学意义的显著改善。两个共同主要终点分别为,与安慰剂联合TCS(无论是否联用TCI)相比,治疗16周后皮损清除(0)或基本清除(1),以及湿疹面积和严重程度指数(EASI)降低75%。20
此外,试验还达到了所有关键的次要终点,证实与安慰剂联合TCS(无论是否联用TCI)相比,Nemluvio®(奈莫利珠单抗)与TCS联用(无论是否联用TCI),可最早在第1周即对瘙痒产生显著疗效,并在统计学上显著改善了睡眠障碍。20
总体而言,Nemluvio®(奈莫利珠单抗)的耐受性良好,安全性在Nemluvio®(奈莫利珠单抗)组和安慰剂组之间基本一致。20
“尽管目前已有多种治疗方案,但特应性皮炎在全球范围内仍有巨大影响。患者不仅要承受剧烈瘙痒和反复皮损的折磨,还可能面临睡眠问题、疼痛、焦虑和抑郁等相关症状。我期待在诊疗实践中,能为这些寻求缓解瘙痒和皮损折磨的特应性皮炎患者提供这一新选择。”ARCADIA临床试验首席顾问和研究人、美国乔治华盛顿大学医学与健康科学学院皮肤病学教授JONATHAN SILVERBERG说。
2024年8月,美国食品药品监督管理局(FDA)还批准了Nemluvio®(奈莫利珠单抗)作为预填充笔,用于皮下注射治疗成人结节性痒疹。12
2024年12月12日,欧洲药品管理局(EMA)下辖人用医药产品委员会(CHMP)通过了一项积极意见,建议在欧盟(EU)批准奈莫利珠单抗用于治疗特应性皮炎和结节性痒疹。21该意见随后将由欧洲委员会审核,该委员会有权批准所有27个欧盟成员国以及冰岛、列支敦士登和挪威的药品上市。此外,高德美关于Nemluvio®(奈莫利珠单抗)治疗特应性皮炎和结节性痒疹的上市许可申请,目前正接受多个监管机构的审评,包括Access Consortium框架下的澳大利亚、新加坡和瑞士等国,以及加拿大、巴西和韩国的监管机构。222025年还将继续向其他监管机构提交申请。
据高德美预计,奈莫利珠单抗的销售峰值将有望超过20亿美元(预计超过2023—2027年中期指导期)。到2027年底,奈莫利珠单抗的净销售额将接近“重磅级”水平。
*说明:截至目前,Nemluvio®(奈莫利珠单抗)尚未在中国市场获批上市
关于 Nemluvio®(奈莫利珠单抗)
Nemluvio®(奈莫利珠单抗)最初由中外制药有限公司开发。2016年,高德美获得了奈莫利珠单抗在全球(日本和中国台湾除外)的独家开发和销售权。在日本,奈莫利珠单抗以Mitchga®的名称销售,获准用于治疗结节性痒疹以及儿童、青少年和成人患者与特应性皮炎相关的瘙痒症23,24。
关于ARCADIA临床试验项目20,25,26
ARCADIA项目包括两项设计相同的关键性三期临床试验(ARCADIA 1和ARCADIA 2),共计招募1700余名患者。
这些全球性、随机、多中心、双盲、安慰剂对照的三期临床试验,评估了每四周皮下注射一次奈莫利珠单抗的疗效和安全性,并与安慰剂进行了比较(两项研究均与基础外用TCS治疗联合,无论是否联用外用TCI)。
试验在患有中度至重度特应性皮炎的青少年和成人患者(12岁及以上)中进行,初始治疗阶段为16周。治疗有反应的患者(定义为研究者的总体评估评分达到“清除”(0)或“基本清除”(1),或湿疹面积和严重程度指数评分改善75%或更多)将被重新随机分配到试验的维持治疗阶段,维持治疗最长持续48周。
关于特应性皮炎
特应性皮炎是一种常见的慢性炎症性皮肤病,以持续瘙痒和反复出现皮损为特征。1-3全球范围内有超过2.3亿人患有这种疾病,它是最常见的炎症性皮肤病之一,患病人数几乎是银屑病的四倍。2,27虽然目前可用的特应性皮炎治疗方法能在一定程度上改善体征和症状,但并非所有患者都能获得相同程度的瘙痒缓解和皮损清除,许多患者对已获批的疗法反应欠佳。2,5-7
关于高德美
高德美(瑞士证券交易所:股票代码为“GALD”)致力于成为专注皮肤学领域的全球领导者,业务遍及约90个国家和地区。我们提供创新、以科学为基础的优质旗舰品牌和服务组合,横跨注射美学、日常护肤和皮肤治疗这三个快速增长的皮肤学细分市场。自1981年成立以来,我们一直热忱专注于人体最大的器官——皮肤,与专业医务工作者合作,以卓越成果满足求美者、消费者和患者的个性化需求。肌肤塑造了我们的人生故事,由此,我们致力于不断推进“每一个进步为每一寸肌肤”。更多信息请访问:www.galderma.com
参考文献
1.Yang G, et al. Skin Barrier Abnormalities and Immune Dysfunction in Atopic Dermatitis. Int J Mol Sci. 2020;21(8): 2867. doi: https://doi.org/10.3390/ijms21082867
2.Langan SM, et al. Atopic dermatitis [published correction appears in Lancet. 2020;396(10253):758]. Lancet. 2020;396(10247):345-360. doi:10.1016/S0140- 6736(20)31286- 1
3.Ständer S. Atopic dermatitis. N Engl J Med. 2021;384(12):1136-1143. doi:10.1056/NEJMra2023911
4.Silverberg JI, et al. Sleep Disturbances in Adults with Eczema Are Associated with Impaired Overall Health: A US Population-Based Study. J Invest Derm. 2015; 135, 56–66; doi:10.1038/jid.2014.325
5.Lobefaro F, et al. Atopic Dermatitis: Clinical Aspects and Unmet Needs. Biomedicines. 2022;10:2927. doi:10.3390/biomedicines10112927
6.Katoh N, Ohya Y, Ikeda M, et al. Clinical practice guidelines for the management of atopic dermatitis 2018. J Dermatol. 2019;46(12): 1053-1101. doi:10.1111/1346-8138.15090
7.Kwatra SG, Misery L, Clibborn C, Steinhoff M. Molecular and cellular mechanisms of itch and pain in atopic dermatitis and implications for novel therapeutics. Clin Transl Immunology. 2022;11(5):e1390. doi:10.1002/cti2.1390
8.Silverberg J, et al. Phase 2B randomized study of nemolizumab in adults with moderate-to-severe atopic dermatitis and severe pruritus. J Allergy Clin Immunol. 2020;145(1):173-182. doi:10.1016/j.jaci.2019.08.013
9.Bağci IS and Ruzicka T. IL-31: A new key player in dermatology and beyond. J Allergy Clin Immunol. 2018;141(3): P858-866. doi: 10.1016/j.jaci.2017.10.045
10.Dillon SR, et al. Interleukin 31, a cytokine produced by activated T cells, induces dermatitis in mice [published correction appears in Nat Immunol. 2005;6(1):114.] Nat Immunol. 2004;5(7):752-760. doi: 10.1038/ni1084
11.Datsi A, et al. Interleukin-31: The “itchy” cytokine in inflammation and therapy. Allergy. 2021;76:2982-2997. doi: 10.1111/all.14791
12.NEMLUVIO (nemolizumab-ilto) injection 30 mg Prescribing Information. Dallas, TX: Galderma Laboratories, L.P.; August 2024
13.Augustin M, et al. Real-World Treatment Patterns and Treatment Benefits among Adult Patients with Atopic Dermatitis: Results from the Atopic Dermatitis Patient Satisfaction and Unmet Need Survey. Acta Derm Venereol. 2022;7: 102:adv00830. doi: 10.2340/actadv.v102.3932
14.Durno N, et al. Biologics and oral systemic treatment preferences in patients and physicians for moderate-to-severe atopic dermatitis: a discrete choice experiment in the United Kingdom and Germany. J Derm Treatment. 2024;35(1). doi: 10.1080/09546634.2024.2417966
15.Penton H, et al. Assessing Response in Atopic Dermatitis: A Systematic Review of the Psychometric Performance of Measures Used in HTAs and Clinical Trials. Dermatol Ther (Heidelb). 2023;13(11):2549-2571. doi: 10.1007/s13555-023-01038-3
16.Silverberg JI, et al. Patient burden and quality of life in atopic dermatitis in US adults: a population-based cross-sectional study. Ann Allergy Asthma Immunol. 2018;121(3):340-347. doi:10.1016/j.anai.2018.07.006
17.Halvorsen J, et al. Suicidal Ideation, Mental Health Problems, and Social Function in Adolescents with Eczema: A Population-Based Study. J Invest Derm. 2014;134: 1847-1854. doi:https://doi.org/10.1038/jid.2014.70
18.Avena-Woods C. Overview of atopic dermatitis. Am J Manag Care. 2017;23(8 suppl):S115-S123. PMID:28978208
19.Hahn EL, Bacharier LB. The atopic march: the pattern of allergic disease development in childhood. Immunol Allergy Clin North Am. 2005;25(2):231-246. doi:10.1016/j.iac.2005.02.004
20.Silverberg J, et al. Nemolizumab with concomitant topical therapy in adolescents and adults with moderate-to-severe atopic dermatitis (ARCADIA 1 & 2): results from two replicate double-blinded, randomised controlled phase 3 trials. Lancet. 2024. doi: 10.1016/S0140-6736(24)01203-0
21.Galderma. CHMP recommends approval of Galderma’s nemolizumab for moderate-to-severe atopic dermatitis and prurigo nodularis in the European Union. Available online. Accessed December 2024
22.Galderma. Galderma receives filing acceptances for nemolizumab in prurigo nodularis and atopic dermatitis in four additional countries. Available online. Accessed December 2024
23.Chugai Pharmaceutical Co., Ltd. Maruho Obtained Regulatory Approval for Mitchga, the first Antibody Targeting IL-31 for Itching Associated with Atopic Dermatitis. Available online. Accessed December 2024
24.Chugai Pharmaceutical Co., Ltd. Mitchga Approved for Itching in Pediatric Atopic Dermatitis and Prurigo Nodularis, for its Subcutaneous Injection 30mg Vials. Available online. Accessed December 2024
25.ClinicalTrials.Gov. Efficacy & Safety of Nemolizumab in Subjects With Moderate- to-Severe Atopic Dermatitis (NCT03985943). Available online. Accessed December 2024
26.ClinicalTrials.Gov. Efficacy & Safety of Nemolizumab in Subjects With Moderate- to-Severe Atopic Dermatitis (NCT03989349). Available online. Accessed December 2024
27.Raharja A, et al. Psoriasis: a brief overview. Clin Med (Lond). 2021;21(3):170-173. doi: 10.7861/clinmed.2021-0257





